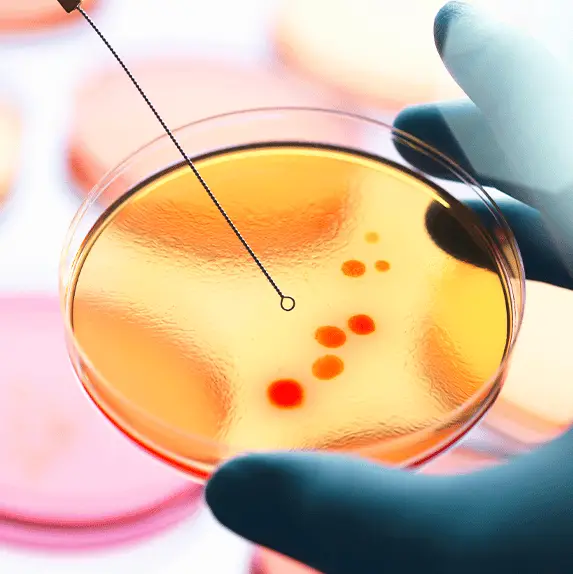
Scientists make breakthrough in process of creating artificial life in the lab
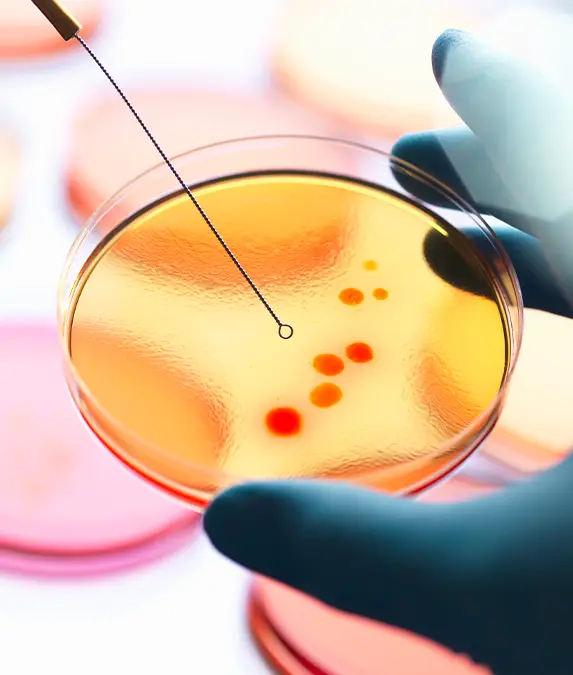
The study may be able to explain early evolution theories / Andrew Brookes / Getty

Scientists may have found a way to create life in the lab.
The theory focuses on the creation of life from spontaneous replication of RNA, known as 'primordial soup'.
The 'RNA World' theory suggests that in the early days of planet Earth, RNA, the single-stranded sister of DNA, was abundant with the purpose of sustaining life.
Now scientists at The Salk Institute for Biological Studies have been able to create an RNA molecule in the lab and make accurate copies of it, resulting in a functioning enzyme.
Advert
'We're chasing the dawn of evolution,' said Gerald Joyce, senior study author and Salk president.

Despite not being self-replicating, the incredible findings mark a huge leap forward to creating life in a lab.
However, if the RNA is able to replicate itself then it 'would be alive.'
Joyce continued: 'This is the road to how life can arise in a laboratory or, in principle, anywhere in the universe.
'By revealing these novel capabilities of RNA, we're uncovering the potential origins of all life, and how simple molecules could have paved the way for the complexity and diversity of life we see today.'
Although we will never get a conclusive answer as to how the earliest types of evolution started on planet Earth, experiments like these show that the process is at least theoretically possible.
The study, published in the journal Proceedings of the National Academy of Sciences, suggests that a type of evolution may have been happening in the RNA World scenario.
It becomes a case of survival of the fittest, the RNA enzymes get better at copying and continue to thrive whilst the lower-quality ones are phased out through the course of evolution, and eventually die out.
Joyce explains that RNA replication is often overlooked when we think about evolutionary biology. Despite RNA always working and being the foundation of our life, DNA tends to take all of the credit.
'We've long wondered how simple life was at its beginning and when it gained the ability to start improving itself,' mentioned first study author Nikolaos Papastavrou, a research associate in Joyce's lab.
'This study suggests the dawn of evolution could have been very early and very simple.
'Something at the level of individual molecules could sustain Darwinian evolution, and that might have been the spark that allowed life to become more complex, going from molecules to cells to multicellular organisms.'